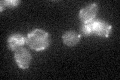
YGL085W
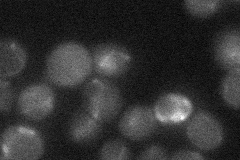
YGL085W
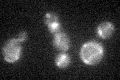
YGL085W
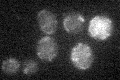
YGL085W

View description
Putative protein of unknown function, has homology to Staphylococcus aureus nuclease; green fluorescent protein (GFP)-fusion protein localizes to mitochondria and is induced in response to the DNA-damaging agent MMS
Localization:
Intensity:
Fold change:
Significance:
-
C’ GFP library in SD
mitochondria21.41 -
N' NOP1pr-GFP in SD

punctate,vacuole,mitochondria21.4252 -
N' TEF2pr-mCherry in SD

below threshold6.49571 -
N' NATIVEpr-GFP in SD
mitochondria17.3594 -
N' TEF2pr-VC and Cyto-VN in SD

#N/A0 -
C’ GFP library in SD+DTT

mitochondria21.350.99No -
C’ GFP library in SD+H2O2
mitochondria19.50.91No -
C’ GFP library in Starvation Media
mitochondria17.520.81Yes -
C’ GFP library on the background of Pup2-DaMP

mitochondria -
C’ GFP library on the background of CCT mutant

mitochondria25.89081.20863No
